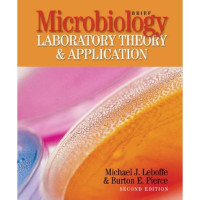
Image of Brief Microbiology Laboratory Theory & Application 2nd Edition

Detail Cantuman
Advanced Search
EBOOK UMUM KESEHATAN
Brief Microbiology Laboratory Theory & Application 2nd Edition
This brief version of the best-selling laboratory manual Microbiology: Laboratory Theory and Application is intended for majors or nonmajors in introductory microbiology laboratory courses. This full-color manual is appropriate for courses populated primarily by allied health students and courses with a preference for an abbreviated number of experiments, student versions of this title are three-hole drilled and in loose-leaf format. Customized for Arkansas State University-Newport
Ketersediaan
Tidak ada salinan data
Informasi Detil
Judul Seri |
-
|
---|---|
No. Panggil |
-
|
Penerbit | Morton Publishing Company : United States of America., 2012 |
Deskripsi Fisik |
578 hlm.; ebook.
|
Bahasa |
English
|
ISBN/ISSN |
978-0-89582-947-4
|
Klasifikasi |
NONE
|
Tipe Isi |
-
|
Tipe Media |
-
|
---|---|
Tipe Pembawa |
-
|
Edisi |
2nd Edition
|
Subyek | |
Info Detil Spesifik |
-
|
Pernyataan Tanggungjawab |
Burton E. Pierce
|
Versi lain/terkait
Tidak tersedia versi lain